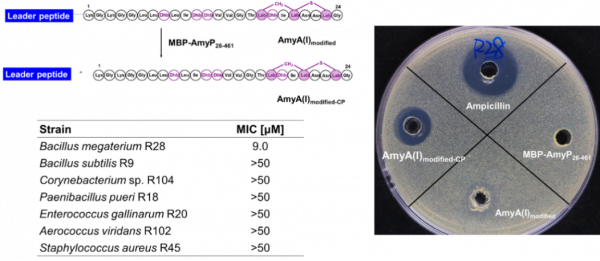
腸道菌群暗藏“江湖”，核糖體肽巧扮“殺器”

在長期共同進化中,腸道菌群與宿主共同構成超級生物體,一起成長,一起變老,度過或長或短的一生。腸道菌群作為超級生物體不可分割的一部分,對宿主有著重要的影響,也因此被喻為“隱形的器官”,這一“器官”健康與否就取決於菌群的種類和結構。由於腸道是這個星球中微生物最為密集的地方之一,這些腸道菌面臨著巨大的“內卷”壓力,它們要如何才能脫穎而出呢?
腸道菌群作為超級生物體不可分割的一部分,對宿主有著重要的影響,它們有的訓練宿主免疫系統躲過追殺(瞞天過海),有的透過轉化宿主代謝物煉製毒藥(借刀殺人)。但是,最有效的“卷”法還是要自己能打,透過苦練修習將武功外化為獨門武器——抗生素,在必要時放倒或者殺死別的腸道菌。
在之前的研究中,科學家發現包括人類在內的動物體內,腸道菌能產生豐富的抗生素武器,形成了血雨腥風的微生物江湖。江湖中不同門派流傳著各自的獨家武功秘籍,又叫生物合成基因簇(Biosynthetic Gene Cluster,BGC)。這些秘籍用ATCG四種字母記載,篇幅有長有短(通常為10-100kb,或者1萬到10萬字)。其中有一大門派,其武功秘籍篇幅較短(1萬字左右)、容易習得,使用的武器叫做“翻譯後修飾核糖體多肽(Ribosomally synthesized Post-translationally modified Peptide, RiPP)。由於RiPP發音和英文中排骨Rib的發音一致,因此江湖人稱“排骨派”。
排骨派聲勢浩大,分舵堂口眾多,說來話長,今天著重講一講叫lanthipeptide的這一分舵,中文名叫羊毛硫肽。其名字來源與羊排是否有關,眾說紛紜,已是謎案,按下不表;但透過研究動物腸道菌中羊毛硫肽分子及其生物合成過程,將有助於解析腸道菌間的相(ai)互(hen)作(qing)用(chou),進而理解菌群種類和結構如何影響宿主疾病和健康。
近期,中國科學院深圳先進技術研究院合成生物學研究所司同課題組和南京大學化學化工學院的王歡課題組合作,在模式動物大鼠腸道菌中發現了一類新穎的窄譜羊毛硫肽抗生素amylopeptins,解析了基因簇內S8家族絲氨酸肽酶AmyP如何參與前導肽移除和抗生素活性的啟用。本工作首次報道了具有特異性識別位點的肽酶可以參與III型羊毛硫肽生物合成過程。
課題組前期從大鼠腸道中分離得到一系列腸道菌株;基於生物資訊學分析,研究人員破譯了這些微生物基因組中可能存在的“武功秘籍”,預測可能存在多個新穎羊毛硫肽基因簇(“不同門派”)。透過菌群互作實驗(“比武”),也進一步推測這些產物可能是具有抗生素活性的“武器”。基於新穎性分析,本工作重點關注Bacillus amyloliquefaciens基因組編碼的一個III型羊毛硫肽基因簇,簇中含有不同的招式:(1)可能對應7種不同產物的7條前體肽;(2)一個新穎III型羊毛硫肽合成酶AmyKC;(3)一個S8家族的絲氨酸肽酶AmyP以及一個轉運蛋白AmyT。如圖1所示。

圖1 基因組挖掘(genome mining)從大鼠腸道菌中得到一個新穎的III型羊毛硫肽基因簇
結合大腸桿菌異源表達和體外生化反應,研究人員成功獲得III型羊毛硫肽產物,結合高分辨質譜、點突變實驗以及化學衍生等手段對多肽的化學結構進行了鑑定:其中AmyA(I)和AmyA(V)均具有labionin的特徵結構而AmyA(VI)則只具有線性的多肽結構。這一結果顯示AmyKC具有良好的底物寬泛性,並能特異性地對多肽進行不同程度的修飾,獲得多樣性的產物。最近的一系列研究表明,同一個羊毛硫肽基因簇合成多種產物似乎是腸道菌羊毛硫肽基因簇的特徵,而在環境菌中較為罕見。這也暗示了腸道中的“微生物江湖”比其他環境更為險惡,微生物不得不隨身攜帶多種武器用於防身。如圖2所示。

圖2 III型羊毛硫肽amylopeptins的結構及其鑑定
攜帶刀劍時必須入鞘,否則難免誤傷自己,而前導肽就是羊毛硫肽的“刀鞘”。因此,前導肽移除是啟用羊毛硫肽功能的重要步驟,但在III型羊毛硫肽生物合成過程相關研究十分有限。本研究中,研究人員發現重組AmyP可以特異性切割簇中編碼的修飾後前體肽,並且結合點突變底物、同源底物實驗鑑定了特異性識別位點。基於序列相似性網路、基因組挖掘等生信分析,研究人員發現這一機制在其他III型羊毛硫肽基因簇中廣泛存在,並透過實驗驗證了AmyP類似蛋白酶的活性。這是S8家族絲氨酸肽酶參與III型羊毛硫肽前導肽特異性移除過程的首次報道。換句話說,研究者發現了這門武功中一種新的拔刀招式。
總結而言,amylopeptins生物合成途徑可以分為兩步,首先,核糖體編碼產生的前體肽經由AmyKC催化的脫水及環化後;之後,修飾後前體多肽由S8家族的絲氨酸肽酶特異性切割,並釋放終產物。如圖3所示。
最後,研究人員對產物之一amylopeptin(I)進行生物活性表徵,共測試了19株不同種屬的大鼠腸道菌。抑菌實驗表明,amylopeptin(I)僅對Bacillus megaterium顯示出明顯活性,可被認為是一種窄譜羊毛硫肽抗生素;而AmyP參與的前導肽移除對抑菌活性啟用非常關鍵(圖4)。有趣的是,Severinov課題組最近也表徵了一個來自於Bacillus、具有額外N端二甲基化的III型羊毛硫肽andalusicin A,也是對兩株Bacillus具有較強抑菌活性,提示微生物利用III型羊毛硫肽進行生態位競爭的現象在自然界中可能廣泛存在。
該研究成果發現了蛋白酶參與的新穎III型羊毛硫肽合成機制,以及腸道特殊生境中展現的窄譜抗生素活性,為天然產物研究領域提供了重要借鑑意義。該研究將結合深圳合成生物研究重大科技基礎設施中的自動化研究平臺,從動物和人類腸道菌群中規模化挖掘和研究活性天然產物,理解其在人類健康和疾病中的作用機制,有望發現新的治療靶點和藥物。
12月10日,中國科學院深圳先進技術研究院司同課題組和南京大學化學化工學院的王歡課題組合作,在國際化學期刊 Angewandte Chemie 中發表了題為Biosynthesis of Gut-Microbiota-Derived Lantibiotics Reveals a Subgroup of S8 Family Proteases for Class III Leader Removal的文章。南京大學博士後章盈盈,合成所助理研究員洪志來、合成所博士後周亮(已出站)為論文共同第一作者,王歡教授和司同研究員為論文共同通訊作者。本工作首次報道了具有特異性識別位點的肽酶可以參與III型羊毛硫肽生物合成過程。

文章連結:Biosynthesis of Gut‐Microbiota‐Derived Lantibiotics Reveals a Subgroup of S8 Family Proteases for Class III Leader Removal - ZHANG - - Angewandte Chemie International Edition - Wiley Online Library
來源:中國科學院深圳先進技術研究院